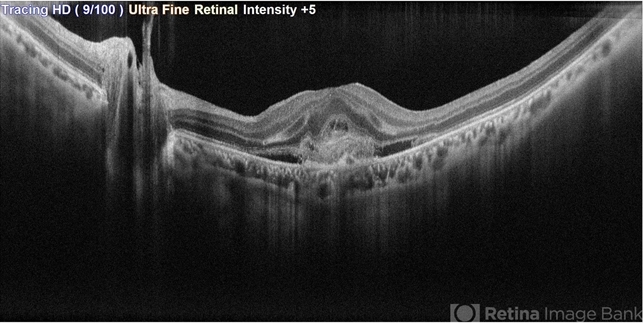
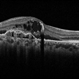
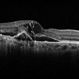

-
 By Vaidehi Sathaye
By Vaidehi Sathaye
Sankalp Hospitals, Jamnagar
Co-author(s): Dr. Manish Nagpal, Retina Foundation , Ahmedabad - Uploaded on Oct 25, 2023.
- Last modified by Joshua Friedman on Oct 26, 2023.
- Rating
- Appears in
- Miscellaneous
- Condition/keywords
- SRNVM, OCT
- Photographer
- Dr. Vaidehi Sathaye
- Imaging device
-
Scanning laser ophthalmoscope
Mirante - Description
- OCT image of a 45 year old female with SRNVM in the LE

Initializing download.
Initializing download.